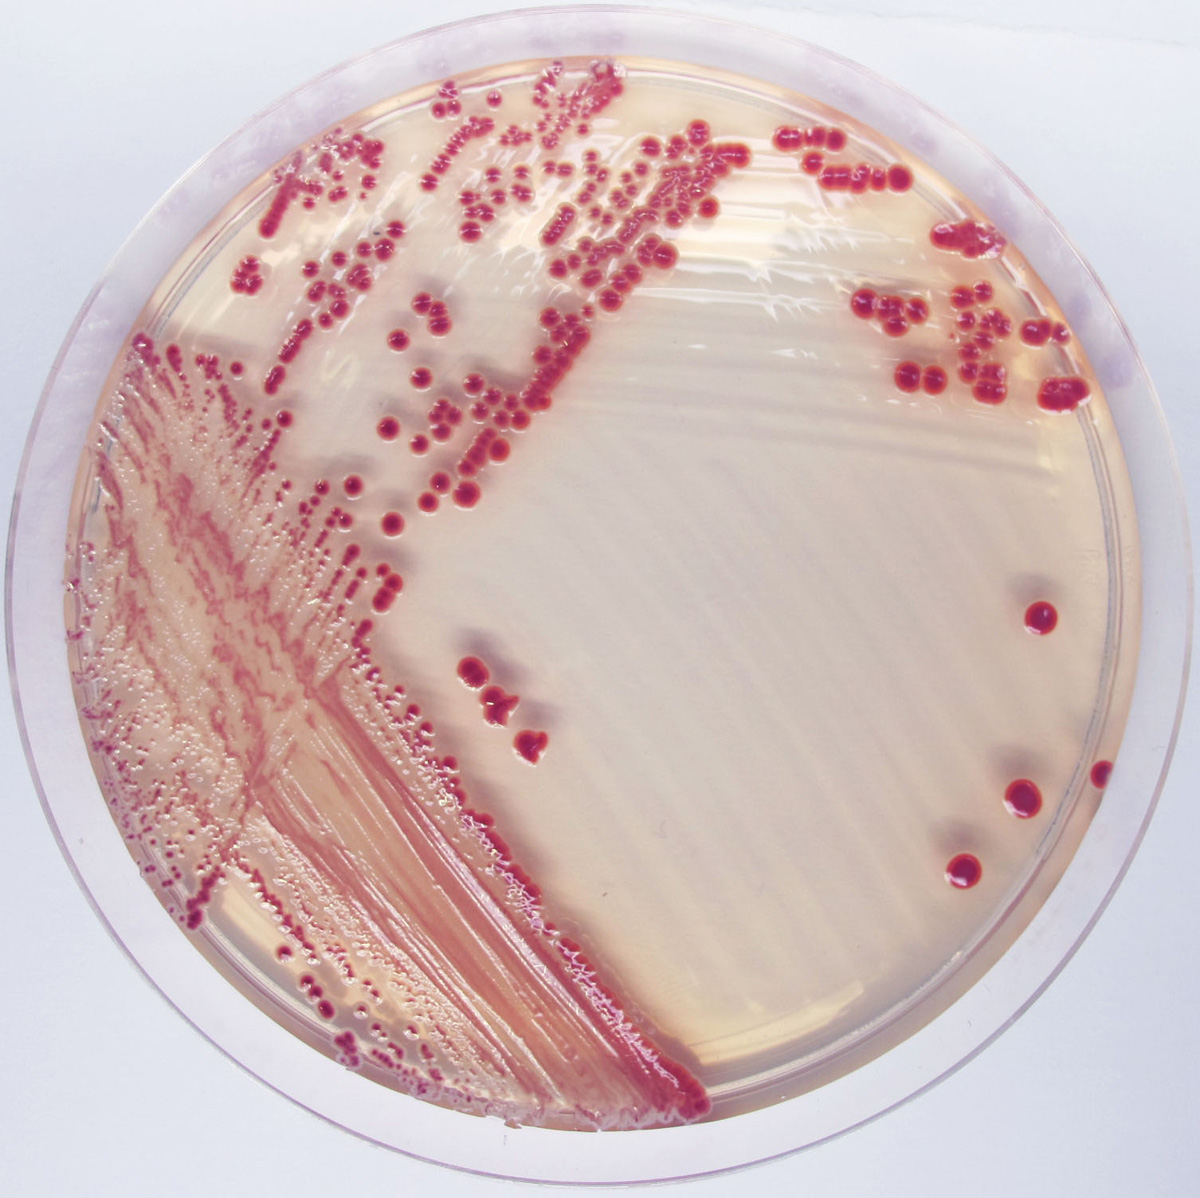
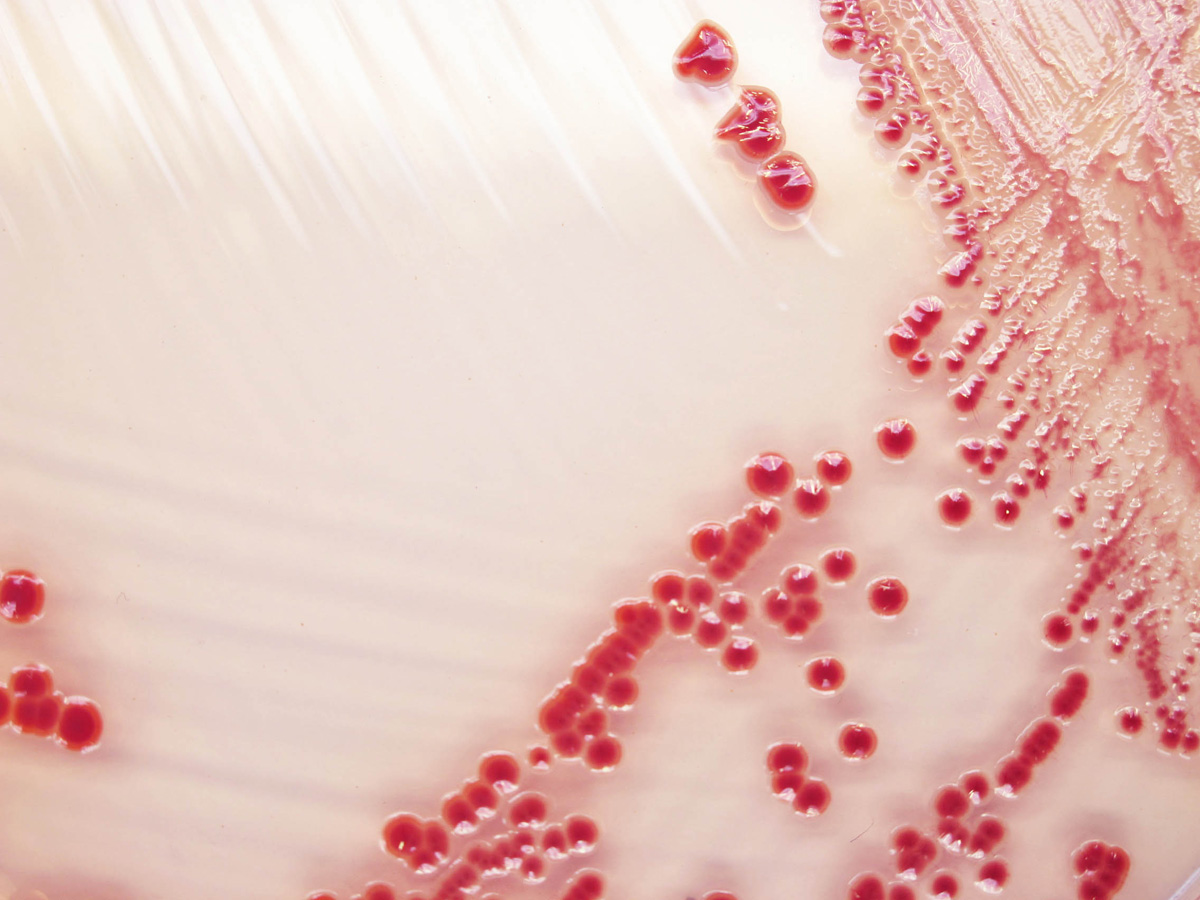
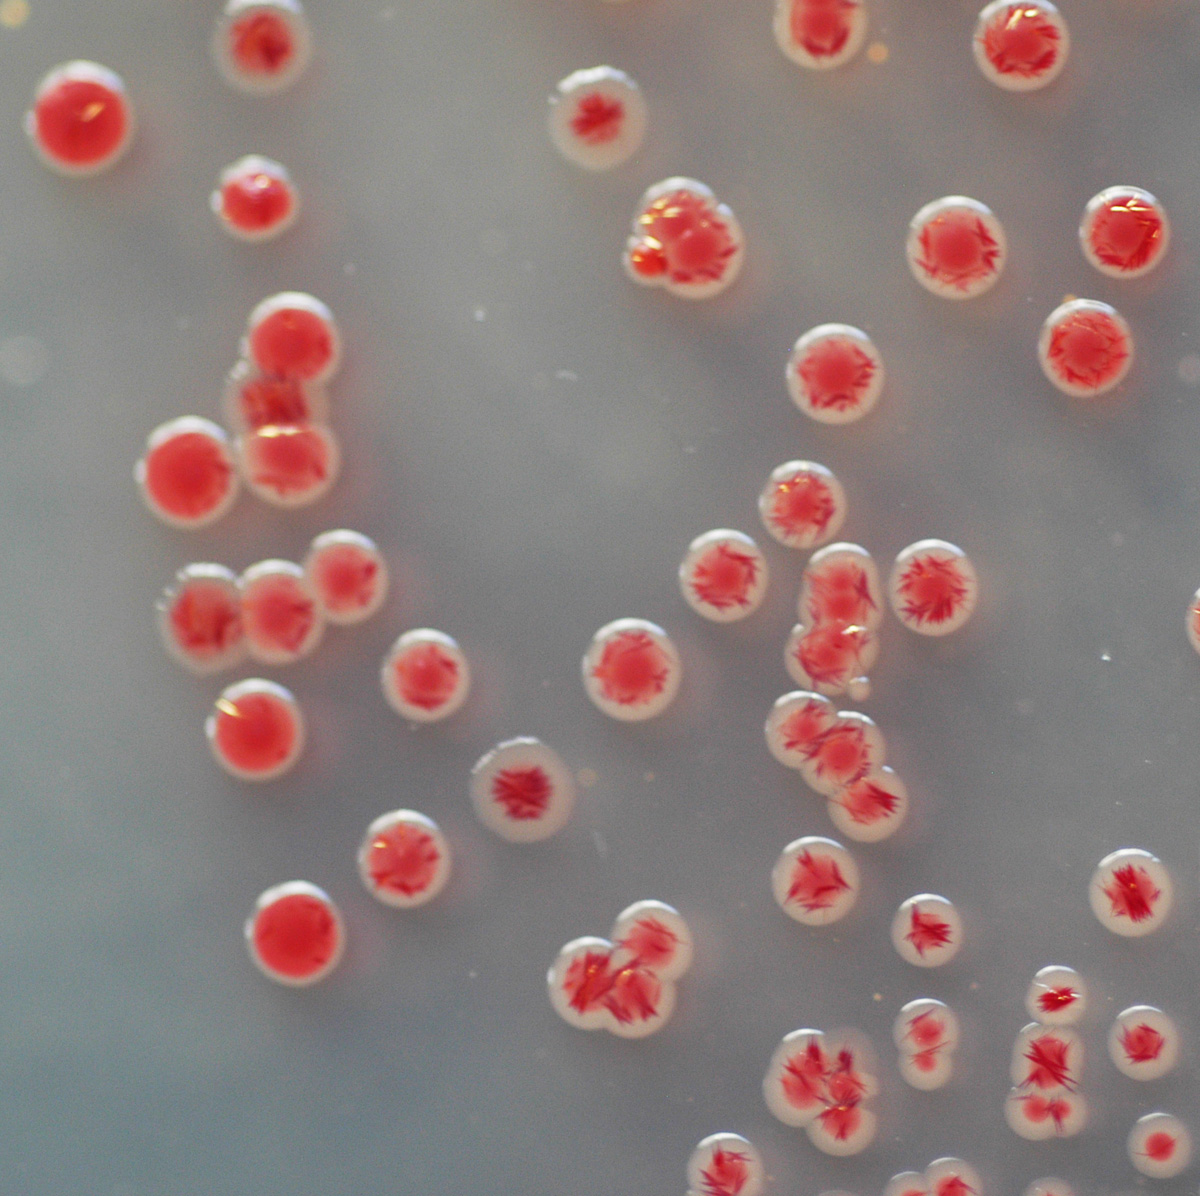

À propos du produit
CHROMagar Acinetobacter est utilisé pour la détection et l’isolement sélectif des Acinetobacter et MDR Acinetobacter sp.
CHROMAGAR ACINETOBACTER MDR

CHROMagar Acinetobacter est utilisé pour la détection et l’isolement sélectif des Acinetobacter et MDR Acinetobacter sp.